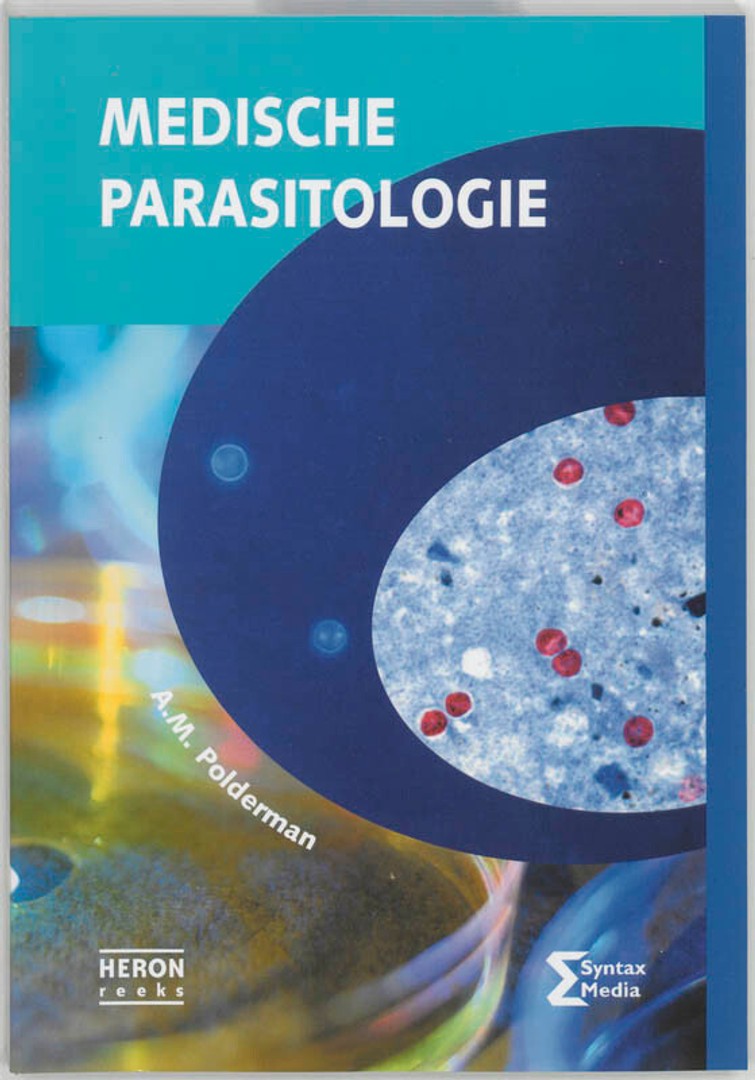
coverImage

Medische parasitologie - A.M. Polderman
handleiding bij de laboratoriumdiagnostiek
Stockfoto

KORTE INHOUD
Een Nederlandstalige, praktisch georienteerde handleiding bij de laboratoriumdiagnostiek van parasitaire infecties. In deze 4e, geheel herziene druk, worden de procedures voor een correcte determinatie van de parasieten, zoals het zuiveren en kleuren en de morfologische herkenning, zeer gedetailleerd beschreven. Daarnaast wordt een aantal meer indirecte methoden omschreven, zoals serologische technieken en antigeen-detectie. Nieuwe technologieën die in ontwikkeling zijn, worden toegelicht.
Ook deze herziene ...
Ook deze herziene ...
Deel:kopieer
Details
2005 Uitgever: Syntax Media Reeks: Heron-Reeks Nummer: vierde editie 218 paginas Taal: Nederlands Grootte: 243x168x21 ISBN-10: 9077423141 ISBN-13: 9789077423141Koop dit boek tweedehands
bij volgende verkopers

